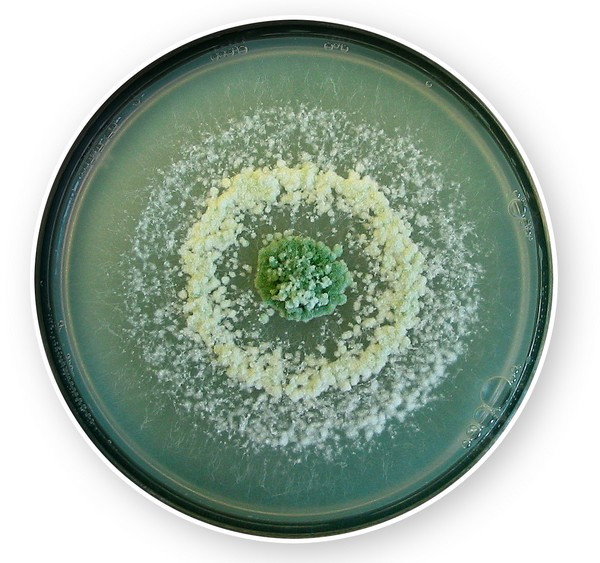

El uso de microorganismos como agentes de biocontrol continúa ganando protagonismo en la agricultura moderna. Entre ellos, el Trichoderma asperellum T34 se ha consolidado como una de las cepas más eficaces, con resultados consistentes en el control de enfermedades del suelo y en la mejora de la salud vegetal.
Desde Biocontrol Technologies, explican en detalle las particularidades de esta cepa, su integración en estrategias de manejo sostenible y su pleno reconocimiento regulatorio dentro de la agricultura ecológica europea.
 © Biocontrol
© Biocontrol
Una cepa con eficacia diferencial: el valor añadido de T34
"Nuestro producto se basa en el microorganismo Trichoderma asperellum, cepa T34. Los productos para la protección de las plantas (PPP) o fitosanitarios basados en microorganismos se registran a nivel de cepa. Las cepas son variaciones genéticas específicas entre microorganismos, que científicamente se diferencian por su fenotipo (morfología, composición bioquímica) y genotipo (secuencias de ADN). Consecuentemente, las características entre cepas son distintas, sus mecanismos de acción y por tanto la eficacia entre cepas es distinta".
T. asperellum T34 se comercializa con distintos nombres, en España bajo las marcas T34 Biocontrol® y Asperello® Biocontrol. "El T. asperellum T34 destaca por su gran persistencia tanto en el suelo como en la rizosfera. En el suelo, actúa parasitando las estructuras de resistencia de los patógenos, lo que comporta una disminución de las poblaciones del patógeno en campañas posteriores. En la rizosfera (la zona del suelo en contacto con la raíz de las plantas) T34 mantiene una excelente interacción con la planta, activando su sistema inmunitario (efecto "vacuna") y favoreciendo una respuesta mayor y más rápida frente al ataque de patógenos y estreses ambientales, permitiendo a la planta alcanzar un desarrollo óptimo y próximo a su potencial genético".
© Biocontrol
© Biocontrol
"Podemos decir que cada cepa de Trichoderma es distinta, aunque todas comparten unas características comunes propias del género y la especie, siendo T34 una de las más eficaces".
"Por último, recomendamos consultar siempre la concentración del producto que se comercializa, así como las dosis autorizadas y número de aplicaciones por cultivo. Solo así puede evaluarse correctamente su eficiencia en relación con su coste y el valor diferencial que aporta T34".
Integración en programas de manejo integrado y agricultura ecológica
T. asperellum T34 es un producto formulado en base a un polvo mojable lo que permite una dispersión homogénea tanto en aplicaciones por riego en el suelo como en tratamientos foliares.
Al estar autorizado como fitosanitario, se puede utilizar perfectamente dentro de estrategias de manejo integrado de enfermedades (IPM) y también en la agricultura ecológica u orgánica. De hecho, dispone de distintas certificaciones europeas, como Ecocert, OF&G, Skal, CAAE y OMRI, que avalan su uso en sistemas de producción sostenible.
 © Biocontrol
© Biocontrol
"T. asperellum T34 es selectivo y seguro para el medio ambiente, ya que no tiene efectos adversos sobre abejas, fauna auxiliar, lombrices, organismos acuáticos ni aves. Durante el proceso de registro fitosanitario se realizaron los estudios ecotoxicológicos pertinentes que confirman esta compatibilidad. Además, T34 no afecta a otros microorganismos beneficiosos del suelo como micorrizas o bacterias fijadoras de nitrógeno, considerados productos fertilizantes según la Regulación (EU) 2019/1009 y clasificados dentro de las categorías PFC 6(A) bioestimulantes y CMC 7 microorganismos".
En programas de manejo integrado de enfermedades, T34 se puede combinar con insecticidas, herbicidas y otros fitosanitarios, pero al tratarse de un hongo vivo, su compatibilidad con fungicidas químicos se debe manejar con cuidado. De forma genérica, se recomienda respetar un periodo de seguridad entre aplicaciones. "En particular, no es compatible con los fungicidas de las familias de los benzimidazoles ni los triazoles, ya que estas moléculas eliminan la cepa T34. Con otros fungicidas químicos, la compatibilidad es parcial: no lo matan, pero puede reducir su crecimiento y eficacia".
 © Biocontrol
© Biocontrol
"En cuanto a otros productos agrícolas, el uso de T34 es compatible en general con extractos naturales y aceites vegetales, así como con fertilizantes minerales, siempre que se controle el pH y la salinidad de la disolución. También puede emplearse junto con otros agentes de control biológico".
"No obstante, respecto a otros bioestimulantes microbianos no recogidos en la Regulación Europea de Fertilizantes (2019) y debido a la falta de definición de especies y cepas que se utilizan en sus formulados, no se recomienda combinarlos, ya que no solo puede ser perjudicial, sino también innecesario".
"Por último, recomendamos consultar a nuestros distribuidores o visitar nuestra web www.biocontroltechnologies.com para obtener información actualizada sobre compatibilidades y programas de aplicación".
Autorización y seguridad: una solución ecológica sin LMR
"Como hemos indicado anteriormente y por las autorizaciones que disponemos, T. asperellum T34 es una sustancia activa segura y plenamente autorizada para su uso en agricultura ecológica.
Además, al no producir fitotoxicidad, a diferencia de muchas moléculas químicas, diversos estudios han demostrado de forma estadísticamente significativa que T34 favorece el crecimiento y la productividad de los cultivos, por ejemplo, en patata y fresa".
 © Biocontrol
© Biocontrol
La sustancia activa T. asperellum T34 se aprobó oficialmente de acuerdo con la Regulación (EC) 1107/2009 con el número 1238/2012 (Diario Oficial de la Unión Europea, 20.12.2012, L350/59) y se comercializa en Europa como producto fitosanitario (PPP) desde el 1 de junio de 2013.
Previamente, en los años 2011 y 2012, la misma sustancia activa se autorizó en Estados Unidos y Canadá, lo que refuerza su reconocimiento internacional.
Asimismo, T34 se encuentra en el Anexo IV del Reglamento (EU) No 396/2005, (Diario Oficial de la Unión Europea 12.06.2015, L147/3), que recoge las sustancias exentas de establecer un Límite Máximo de Residuos (LMR).
"Esto significa que T34 no deja residuos ni en los frutos, ni en el suelo, ni en las plantas. En Estados Unidos, de igual forma, se considera exento de residuos".
Han participado en esta entrevista:
- Dra. María Isabel Trillas i Gay, socia fundadora de Biocontrol Technologies y descubridora de la cepa T34 de T. asperellum. Profesora Emérita de la Universidad de Barcelona, de la sección de Fisiología Vegetal de la Facultad Biología. Directora Científica de la Cátedra UB – Biocontrol Technologies de Microrganismos para la Agricultura.
- Dr. Guillem Segarra i Braunstein, Profesor Lector (Programa Serra Húnter) de la Sección de Fisiología Vegetal de la Universidad de Barcelona. Director Adjunto de la Cátedra UB – Biocontrol Technologies de Microrganismos para la Agricultura.
- Sr. Jordi Fumadó i Llambrich, Coordinador Comercial de Biocontrol Technologies
- Sr. Eduard Fernando i Martínez, Director General de Biocontrol Technologies
 Para más información:
Para más información:
Biocontrol Technologies
Av. Madrid 215-217
08014 Barcelona (Spain)
Tel.: +34 934 09 18 48
[email protected]
https://biocontroltechnologies.com/










